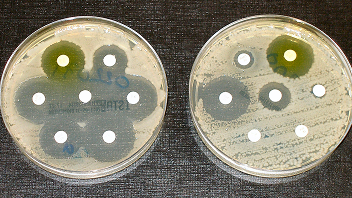

The future of personalized medicine
Advances in data and genomics are allowing treatments tailored to each patient’s unique biology.
The hidden costs of sleep deprivation
Chronic lack of sleep is linked to heart disease, obesity, and mental health issues.
Cancer care breakthroughs: immunotherapy on the rise
Immunotherapy is offering new hope by teaching the body’s immune system to fight cancer cells.
Wearable tech: from fitness to lifesaving tools
Smartwatches and health trackers are evolving into medical-grade monitoring devices.
CRISPR and the future of genetic medicine
Gene editing could eliminate hereditary diseases, but it also raises ethical dilemmas.
Mental health in the digital age
Social media and technology are reshaping mental health—for better and for worse.
Telemedicine: the doctor will see you now—on your phone
Virtual consultations are breaking down barriers to healthcare, making it more accessible than ever.
Robotic surgery: precision at the push of a button
Robots are assisting surgeons in performing complex procedures with minimal invasiveness and faster recovery.
The global challenge of antibiotic resistance
Overuse of antibiotics has created superbugs, posing one of the greatest threats to modern medicine.